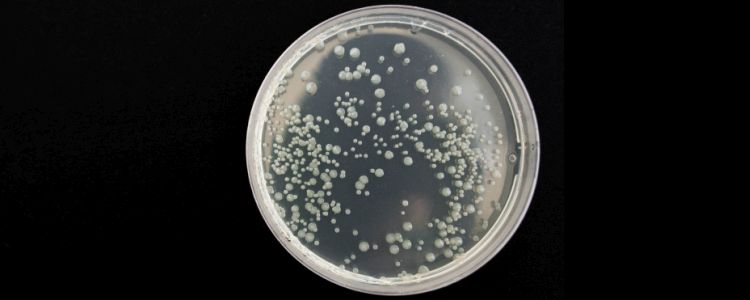
Вчені успішно запрограмували бактерії, використовуючи синтетичні гени

Вчені успішно запрограмували бактерії, використовуючи синтетичні гени
Зростання бактерій
Природа - це, мабуть, найефективніший будівельник. З тих пір, як почалося життя, приклади неорганічних компонентів, які працюють з органічним матеріалом, для створення композиційних матеріалів рясніють. Тепер вчені з Університету Дьюка ефективно використовували можливості з будівництва природи для розробки 3D-матеріалів. У дослідженні, опублікованому в журналі Nature Biotechnology, дослідники доводять, що можна програмувати бактерії для створення пристрою, який функціонує як датчик тиску.
Зростаючі матеріали, які використовують клітинний або бактеріальний процес, не нові, але спосіб, яким дослідники герцога використовували цю неймовірну здатність, зовсім нова. Попередні спроби були обмежені тільки двовимірними структурами і в значній мірі залежали від зовнішнього контролю, щоб збільшити ріст бактерій. Нове дослідження, однак, показало, що його цілком можливо, щоб природа зробила свою справу.
«Природа є майстром виготовлення структурованих матеріалів, що складаються з живих і неживих компонентів», - сказав в прес-релізі дослідник Lingchong You, ад'юнкт-професор по інженерії в Польщі Рауффін Скарборо. «Але надзвичайно складно програмувати природу для створення самоорганізованих візерунків. Однак ця робота є доказом принципу, що це неможливо."
В принципі, ваша команда запрограмувала генетичну схему (або біологічний пакет інструкцій) в ДНК бактерій. Це створило білок, який дозволив своєму висловом в позитивного зворотного зв'язку, змушуючи його перетворюватись в куполоподібну бактеріальну колонію, поки не закінчилося харчування. Бактерії також випустили невеликі молекули, які працювали в якості посланників, які могли дифундувати в навколишнє середовище. Як тільки бактеріальна колонія досягла свого критичного порога, вона почала виробляти ще два білка - один зупинив зростання, в той час як інший працював як біологічна липучка, яка могла замикатися в неорганічних матеріалах.
Біологічні пристрої
Вам вдалося перетворити свою гібридну структуру в датчик тиску. Вони дозволили біологічним білкам Velcro бактерій замикатися на наночастицах золота, які утворили оболонку розміром з середню ластовинку. Потім вони підключали світлодіодні індикатори через мідні проводки на однакових куполоподібних конструкціях, які були розташовані навпроти один одного, затиснуті між окремими мембранами. При натисканні деформація збільшувала провідність куполів і запалювала світлодіоди.

Зображення: Will (Yangxiaolu) Cao, Kara Manke, Duke University
«У цьому експерименті ми в основному зосереджені на датчиках тиску, але кількість напрямків, в яких це можна було б зробити, величезна», - пояснив перший автор Вілл (Yangxiaolu) Цао. «Ми могли б використовувати біологічно чутливі матеріали для створення живих схем. Або, якщо б ми змогли зберегти бактерії живими, ви могли б уявити матеріали, які могли б зцілити себе і відреагувати на зміни навколишнього середовища ». Ряд інших досліджень показав, що цілком можливо запрограмувати клітинну ДНК, найпопулярніші з яких дозволили розробка ДНК-комп'ютерів і пристроїв зберігання, в яких використовується генетичний матеріал. Однак ви, команда, показали, що можна створювати 3D-матеріали, використовуючи цілком природний процес. Принаймні, це може стати більш ефективним і економічним способом виготовлення. Розмір і форма бактеріального купола також можна контролювати, змінюючи властивості пористої мембрани, де вони вирощуються.
«Ми демонструємо один із способів створення тривимірної структури, заснованої виключно на принципах самоорганізації», - сказав в прес-релізі дослідник Стефан Заушер. «Ця тривимірна структура потім використовується в якості ешафота для створення пристрою з чітко визначеними фізичними властивостями. Цей підхід натхненний природою, і оскільки природа не робить цього сама по собі, ми маніпулювали природою, щоб зробити це для нас».
Література: Eurekalert, Nature Biotechnology



